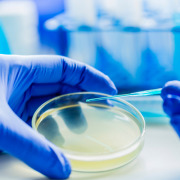
BACTOagar - bacto grade agar

agarTC - technical grade agar
Product description
Technical grade agar that undergoes additional processing to achieve high gel strength and optimal transparency.
Suitable for application: plant tissue culture and capsules
Read more
Suitable for application: plant tissue culture and capsules
Specifications
| Categories | Dietary Fibres, Prebiotics | Dietary fibresAgar; Additives incl. Flavourings & ColoursEmulsifiers, Stabilisers, Thickeners; Algae, Botanicals, Carotenoids, Flavonoids | AlgaeOther Algae; Finished Food CategoriesPlant-based foods |
|---|---|
| Sales markets | Western Europe; Eastern Europe; Middle East; Asia; Australia; North America; Africa; Central/South America |
| Supplied from | Indonesia; Italy |
| Certifications | Health & Safety |
Products from other suppliers
❮
❯
-

Sea Cucumber & Oyster Tablet
-

Bifidobacterium longum BORI
-

Pep2Dia®, new bioactive ingredient that regulates blood sugar levels after meals.
-

CRISPYTEC Series
-

GLP-1 Probiotics - Akkermansia muciniphila AH39 & Lactobacillus casei CCFM419
-

BiPRO® 9500 whey protein isolate (WPI)
-

Crispact® Stick packs
-

Nextida® GC
-

Gasbet tablets
-

NEUROMAX®
agarTC - technical grade agar